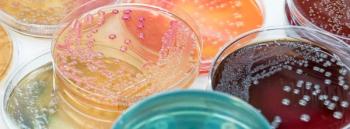
Cultures AdobeStock_123657883 by analysis121980

Joshua Rhein, MD, explains why patients who are obese are more likely to develop sepsis.

Joshua Rhein, MD, explains why patients who are obese are more likely to develop sepsis.

Joshua Rhein, MD, assistant professor of medicine at the University of Minnesota, discusses whether obesity affects vaccine response and what can be done.

Learn from your mistakes; reach for the stars. We all have learning to do. Just don't quit!

Saskia v. Popescu, PhD, MPH, MA, CIC, gives the latest on Candida auris, Marburg Virus Disease, and eye drops from EzriCare and Delsam Pharma.
Reducing unnecessary and inappropriate urine cultures through EHR-focused interventions would be valuable in health care systems that have limited resources.

Take 5 minutes to catch up on Infection Control Today®’s highlights for the week ending March 26, 2023.

Please meet the 2023 Infection Control Today Editorial Advisory Board.

Doe Kley, MPH, RN, CIC, LTC-CIP, T-CHEST speaks with ICT® on narrowing down how many disinfecting products their facilities should have and the education that they need about the cleaners and checking their competency in using those products.

The HAC and Hospital VBP penalties were suspended during the COVID-19 pandemic but are now back in place. Are they forcing hospitals to rethink/reestablish previous practices, and what is the impact?

NIH News Release: "...findings suggest that SARS-CoV-2 infection damages the CD8+ T cell response, an effect akin to that observed in earlier studies showing long-term damage to the immune system after infection with viruses such as hepatitis C or HIV."

Recently, an outbreak of Marburg virus disease occurred in Equatorial Guinea. Infection Control Today® learned more about this rare but severe and often fatal disease and what is being done to combat it.

Take 5 minutes to catch up on Infection Control Today®’s highlights for the week ending March 19, 2023.

Is the global community in danger of a fungal pandemic, as portrayed in the series The Last of Us? Infection Control Today® finds out.

With all the misinformation and confusion about what The Joint Commission (TJC) does and doesn't do, ICT went to TJC to find out. Listen to the detailed interview to find out what health care workers need to know.

A new study focuses on insights that can be used to create interventions for better hand hygiene adherence among all medical professionals.

Doe Kley, MPH, RN, CIC, LTC-CIP, T-CHEST, continues her interview with ICT about why IPs' involvement with their facility's cleaning and disinfection programs is so critical.

Saskia v. Popescu, PhD, MPH, MA, CIC, gives updates on congenital syphilis, skunks and H5N1, and COVID-19 on this Ides of March.

Pfizer's COVID-19 vaccine must be administered at least 2 months after the primary vaccination series.

Infection Control Today's® Product Locator is a monthly column highlighting some of the latest advanced technology in the infection prevention field.

Human Metapneumovirus (HMPV) is not as well-known as its relative, respiratory syncytial virus (RSV), so here is the information that infection control and prevention personnel need to know about this respiratory virus.

How did first responders and firefighters navigate the COVID-19 pandemic and its aftermath? Two firefighters/EMTs describe what that time was like for them.

Preventing health care-associated infections (HAIs) is a principal objective in health care. Obesity is a patient factor that can contribute to the risk of HAIs.

Hepatitis B prevention needs more real-world studies, according to an expert who gave a presentation at CROI.

Dapivirine Vaginal Ring is a form of HIV prevention in cisgender women during pregnancy approved in several African countries and recommended by the WHO.

Doe Kley, MPH, RN, CIC, LTC-CIP, T-CHEST, does a deep dive into what the key priorities infection preventionists and environmental hygienists should focus on in 2023. This is the first of 3 installments.